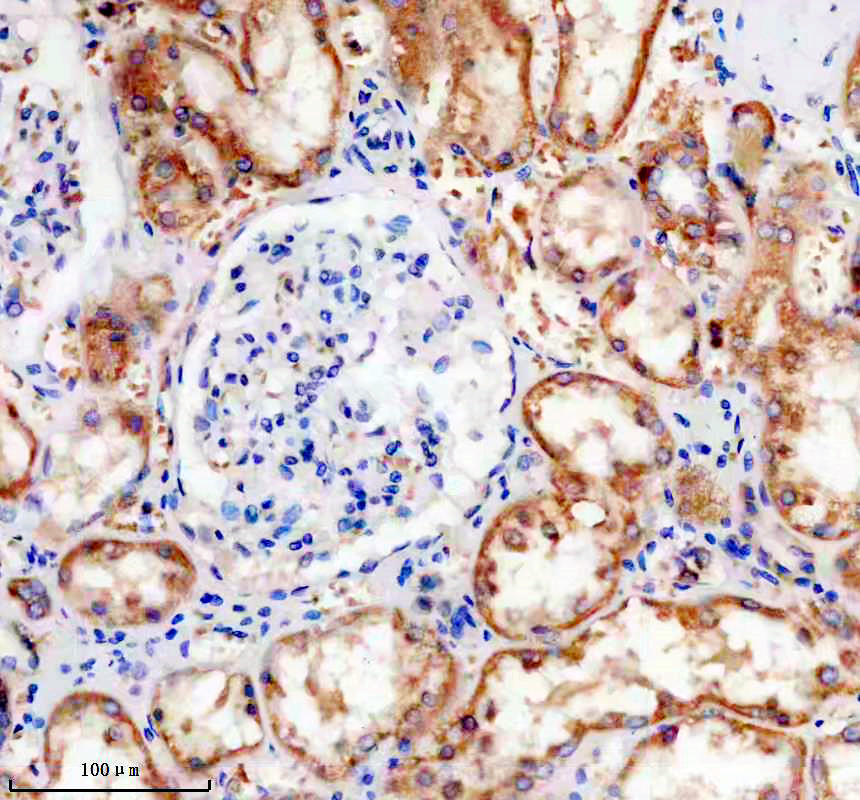

| Western blot (WB): | 1:500-2000 |
| Immunohistochemistry (IHC): | 1:50-200 |
| Immunocytochemistry/Immunofluorescence (ICC/IF): | 1:50-200 |
| ImmunoPrecipitation (IP): | 1:20 |

Western blot analysis of Phospho-Tau (S324) expression in (1) SH-SY5Y cell lysate; (2) SH-SY5Y cell lysate treated with Okadaic acid and Calyculin A.

IHC analysis of TAU/MAPT (Phospho-S324) using anti-TAU/MAPT (Phospho-S324) antibody (BM5195).
TAU/MAPT (Phospho-S324) was detected in a paraffin-embedded section of human kidney tissue. The tissue section was incubated with rabbit anti-TAU/MAPT (Phospho-S324) Antibody (BM5195) at a dilution of 1:200 and developed using HRP Conjugated Rabbit IgG Super Vision Assay Kit (Catalog # SV0002) with DAB (Catalog # AR1027) as the chromogen.

Western blot analysis of Phospho-Tau (S324) expression in (1) SH-SY5Y cell lysate; (2) SH-SY5Y cell lysate treated with Okadaic acid and Calyculin A.

IHC analysis of TAU/MAPT (Phospho-S324) using anti-TAU/MAPT (Phospho-S324) antibody (BM5195).
TAU/MAPT (Phospho-S324) was detected in a paraffin-embedded section of human kidney tissue. The tissue section was incubated with rabbit anti-TAU/MAPT (Phospho-S324) Antibody (BM5195) at a dilution of 1:200 and developed using HRP Conjugated Rabbit IgG Super Vision Assay Kit (Catalog # SV0002) with DAB (Catalog # AR1027) as the chromogen.